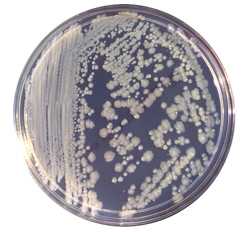
enterobacter cloacae

Диагностика энтеробактерий. Выявление энтеробактерий. Диагностические подходы для энтеробактерий.
Добавил пользователь Евгений Кузнецов Обновлено: 28.11.2025
Энтеробактер (лат. Enterobacter) — род грамотрицательных палочкообразных перитрихиальных споронеобразующих бактерий, факультативных анаэробов. Энтеробактеры входят в состав нормальной микрофлоры кишечника человека.
Энтеробактер также обитает в кишечнике некоторых видов животных, встречается в почве, воде, пищевых продуктах.
Энтеробактер относится к так называемым колиформным бактериям.
Энтеробактер — возбудитель заболеваний человека
Энтеробактер встречается в толстом кишечнике многих здоровых людей, но он относится к условно-патогенным бактериям и при попадании энтеробактера в другие органы возможно развитие инфекционных заболеваний. Ряд видов энтеробактера (Enterobacter agglomerans, Enterobacter cloacae и др.) вызывают инфекционные заболевания почек и мочевыводящих путей (острый пиелонефрит, обострение хронического простатита), половых органов, респираторной системы.
Энтеробактер является одной из самых частых причин внутрибольничных ангиогенных инфекций и инфекций дыхательных и мочевыводящих путей.
Энтеробактер в анализе мочи
Бактериурия — наличие бактерий в моче может является признаком воспаления в мочевыводящих путях, мочевом пузыре, почках. При отсутствии каких-либо симптомов, истинная бактериурия (инфекция мочевых путей) диагностируется при наличии не менее 10 5 микробных тел энтеробактеров (или других энтеробактерий) в 1 мл свежевыпущенной мочи, иначе предполагается, что загрязнение мочи происходит при ее заборе. Если бактериурия не сопровождается какими-либо симптомами, тогда она называется бессимптомной бактериурией. Бессимптомная бактериурия не всегда требует немедленного лечения.
При наличии симптомов или при заборе мочи катетером диагностический порог может быть значительно уменьшен. В частности, при наличии соответствующей клинической симптоматики (лихорадка, озноб, тошнота, рвота, боли в поясничной области, дизурия) и выделении не менее 10 лейкоцитов в 1 мкл мочи, критерием для диагностики острого пиелонефрита является наличие не менее 10 4 энтеробактеров (или других уропатогенных энтеробактерий) в 1 мл мочи.
Энтеробактер в результатах анализа кала на дисбактериоз
При микробиологическом анализе кала энтеробактер рассматривается в комплексе с другими условно-патогенными бактериями, относящимися к семейству энтеробактерии и входящими в состав нормальной микрофлоры кишечника человека (кроме энтеробактера это клебсиелла, протей, гафния, серратия, морганелла, провиденция, цитробактер и др). В норме общее количество этих бактерий (колониеобразующих единиц, КОЕ) в 1 г кала должно быть меньше 10 4 . Большее количество перечисленных микроорганизмов является признаком дисбактериоза.
При избыточном росте энтеробактера, как следствии дисбактериоза, при медикаментозной терапии применяются различные пробиотки (Бифидумбактерин, Бифиформ, Лактобактерин, Ацилакт, Аципол и др.) и/или адекватные конкретному штамму энтеробактера и причине дисбактериоза антибиотики.
Антибиотики, активные в отношении энтеробактера
Антибактериальные средства (из имеющих описание в данном справочнике), активные в отношении энтеробактера: рифаксимин, ципрофлоксацин, норфлоксацин, офлаксацин, нифурател. В отношении Enterobacter cloacae активны: левофлоксацин, моксифлоксацин.
Энтеробактер в систематике бактерий
Род энтеробактер (Enterobacter) входит в семейство энтеробактерии (Enterobacteriaceae), порядок энтеробактерии (Enterobacteriales), класс гамма-протеобактерии (γ proteobacteria), тип протеобактерии (Proteobacteria), царство бактерии.
Диагностика энтеробактерий. Выявление энтеробактерий. Диагностические подходы для энтеробактерий.
Клиника инфекций вызванной энтеробактериями. Диагностика, лечение
Выделяют два вида сальмонелл: Salmonella enterica и Salmonella bongori. Вид Salmonella enterica включает подвиды: enterica, salamae, arizonae, diarizonae, houtenae. Наиболее патогенны для человека и других теплокровных животных серовары подвида enterica.
Сальмонеллёз. Сальмонеллы хорошо приспособлены к обитанию в организме различных животных. У человека инфекция обычно не выходит за пределы кишечника. Заболевание характеризуется саморазрешающейся диареей. В некоторых случаях микроорганизмы могут вызывать инвазивные, угрожающие жизни человека заболевания, сопровождающиеся бактериемией, септицемией и остеомиелитом.
Сальмонелл обнаруживают в организме большинства домашних животных. Важными источниками инфекции считают больных людей и реконвалесцентных носителей. Механизм передачи заболевания — фекально-оральный (при употреблении контаминированных продуктов питания). Самые тяжёлые случаи сальмонеллёза наблюдают у пациентов со сниженным иммунитетом и сниженной секрецией желудочного сока, а также у лиц, перенёсших спленэктомию. В некоторых случаях заболевание осложняется реактивным артритом или развивается хроническое носительство.
Брюшной тиф. Возбудители брюшного тифа — серовары typhi и paratyphi подвида Salmonella enterica. Заболевание характеризуется поражением стенки кишечника, затем регионарных лимфатических узлов, сопровождается первичной бактериемией и инфекцией ретикулоэндотелиальной системы. В последующем бактерии попадают в кишечник из жёлчного пузыря, размножаются в пейеровых бляшках (развивается вторичная бактериемия), вызывают изъязвление стенки кишечника, которое может привести к кровотечению или перфорации. Пациенты предъявляют жалобы на высокую температуру, нарушение функций кишечника (диарею или запор) и сыпь (розеолёзные элементы на передней брюшной стенке). Наблюдают гепатоспленомегалию. Иногда брюшной тиф осложняется остеомиелитом и реже менингитом.
Инфекции мочевыводящих путей и пиелонефрит. Большинство инфекций мочевыводящих путей вызвают определённые серотипы Escherichia coli. Они способны к повышенному образованию К-антигена и гемолизина и прикреплению к эпителию мочевыводящих путей посредством пилей (последнее свойство характерно и для некоторых видов протея). При наличии у возбудителя маннозоустойчивых пилей развивается пиелонефрит. Важный фактор вирулентности бактерий рода Proteus — уреаза, снижающая рН и стимулирующая процесс образования камней.
Менингит и абсцессы мозга. Важной причиной менингита у новорождённых (характеризуется высокой смертностью) является Escherichia coli, штаммы которой в большом количестве продуцируют капсульный Kl-антиген. Кроме того, заболевание может быть следствием нейрохирургических вмешательств, операций по протезированию. Следует отметить, что энтеробактерии очень часто присутствуют в патогенной микрофлоре, сопровождающей абсцессы головного мозга.

Возбудитель сальмонеллеза - Salmonella enterica
Остеомиелит и септический артрит. Тяжелейшее осложнение у пациентов с серповидно-клеточной анемией и ВИЧ-инфекцией — остеомиелит или септический артрит, вызванные сальмонеллами. Кроме того, сальмонеллы и другие энтеробактерии часто вызывают инфекции костей и суставов у пожилых пациентов. Иногда эти заболевания возникают вследствие проникающего ранения. Для лечения обычно применяют фторхинолоны, так как они обладают способностью проникать в костную ткань (например, ципрофлоксацин).
Инфекции, вызванные представителями рода Klebsiella. Микроорганизмы рода Klebsiella обычно вызывают внутрибольничные инфекции. Кроме того, они могут быть причиной развития пневмонии (особенно у пациентов, находящихся на искусственной вентиляции лёгких), инфекций мочевыводящих путей, раневых инфекций и бактериемии. У высоковосприимчивых пациентов известны случаи заболеваний, сопровождающихся септицемией и заканчивающихся летальным исходом. Первичная пневмония, вызванная подвидом Pneumoniae вида К. pneumoniae, — редкое и крайне тяжёлое внебольничное заболевание, характеризующееся неблагоприятным исходом. Возбудитель прогрессирующей гранулематозной инфекции слизистой оболочки полости носа — Klebsiella rhinoscleromatis. Большинство случаев заболевания регистрируют в тропических регионах мира. Другой вид — Klebsiella ozanae — возбудитель хронической бронхо-эктатической болезни.
Инфекции, вызванные бактериями родов Enterobacter, Serratia и Citrobacter. Представители этих родов обитают в окружающей среде и могут поражать пациентов лечебных учреждений, вызывая раневые инфекции, бактериемию и внутрибольничную пневмонию. Выбор антибактериального препарата осложняется тем, что большинство возбудителей устойчиво к действию антибиотиков.
Диагностика энтеробактерий:
• Бактериологическое исследование крови или костного мозга (особенно в диагностике брюшного тифа).
• Изучение биохимических свойств возбудителя (например, способности расщеплять углеводы).
• Серотипирование (серотипы различают по липополисахаридному (О) и жгутиковому (Н) антигену) и фаготипирование применяют при эпидемиологических исследованиях.
• Колицинотипирование.
• Современные молекулярно-генетические исследования.
Лечение и профилактика инфекции вызванной энтеробактериями
Большинство грамотрицательных энтеробактерии чувствительны к действию аминогликозидов, цефалоспоринов широкого спектра действия, фторхинолонов, бета-лактамов и карбапенемов (например, меропенем). Лечение назначают только после определения чувствительности возбудителя к антимикробным средствам, так как некоторые микроорганизмы способны вырабатывать бета-лактамазу и ферменты, разрушающие аминогликозидные препараты. Возросшая в последнее время устойчивость энтеробактерии к антибиотикам широкого спектра действия обусловлена появлением штаммов, обладающих бета-лактамазами широкого спектра действия.
Препараты выбора при инфекциях мочевыводящих путей — цефалексин, ампициллин, нитрофурантоин или триметоприм.
Для профилактики заболеваний, сопровождающихся диареей, необходимо соблюдать правила личной гигиены, приготовления пищи, а также использовать безопасные источники водоснабжения. Основной метод лечения — пероральная регидратация организма.
Препарат выбора при брюшном тифе — ципрофлоксацин, альтернативные средства — триметоприм или цефалоспорины третьего поколения. В некоторых странах инфекционисты сталкиваются с заболеваниями, вызванными мультирезистентными штаммами возбудителя. Для профилактики заболевания людям, посещающим эти регионы, рекомендуют использовать живую аттенуированную (Ту21А) или бесклеточную (содержит Vi-антиген) вакцины, но вакцинация лишь частично защищает от инфекции.
Видео строение, микробиология возбудителя брюшного тифа (S. typhi)
Редактор: Искандер Милевски. Дата обновления публикации: 18.3.2021
Нужен полный текст и статус документов ГОСТ, СНИП, СП?
Попробуйте профессиональную справочную систему
«Техэксперт: Базовые нормативные документы» бесплатно
МЕТОДИЧЕСКИЕ УКАЗАНИЯ
по микробиологической диагностике заболеваний, вызываемых энтеробактериями
Методические указания разработаны:
Центральным Ордена Ленина институтом усовершенствования врачей Минздрава СССР (С.Д.Татаринова);
Центральным научно-исследовательским институтом эпидемиологии Минздрава СССР (В.А.Килессо, Н.С.Прямухина, Ю.Я.Тендетник, Г.В.Ющенко);
Центральным научно-исследовательским институтом вакцин и сывороток имени И.И.Мечникова Минздрава СССР (И.В.Голубева, Б.С.Киселева, Н.А.Хоменко);
Санитарно-эпидемиологической станцией Московской железной дороги (Ю.М.Крюков)
Килессо В.А., д.м.н., профессор
Прямухина Н.С., к.м.н. (заместитель председателя)
Татаринова С.Д., к.м.н., доцент (председатель)
Томашевич В.А., к.м.н. (секретарь)
Заместитель министра здравоохранения СССР П.Н.Бургасов 17.12.1984.
ВВЕДЕНИЕ
За последние 15-20 лет в научных и практических учреждениях нашей страны предложены и апробированы эффективные и научно обоснованные методы выделения и идентификации энтеробактерий. Разработаны и частично внедрены в производство новые диагностические препараты: питательные среды, сыворотки, высокоспецифические диагностикумы, системы для ускоренной идентификации, препараты бактериофагов и некоторые другие реагенты.
В представленный документ включены методы классической бактериологической диагностики заболеваний, вызываемых энтеробактериями, ускоренные методы идентификации и выявления антигенов энтеробактерий, а также методы серологической диагностики соответствующих заболеваний и сведения о приготовлении ряда необходимых питательных сред.
"Методические указания. " преследуют цель унификации методов проведения лабораторной диагностики с применением современных приемов, позволяющих идентифицировать любые из известных в данное время представителей энтеробактерий*. Внедрение в практику данных методических указаний будет способствовать повышению уровня микробиологической диагностики в стране.
* "Инструкцию по микробиологической диагностике кишечных заболеваний, вызванных шигеллами, сальмонеллами и энтеропатогенными кишечными палочками", утв. нач. ГСЭУ Минздрава СССР 11.05.66 г. N 629-66, считать утратившей силу.
В "Методических указаниях. " представлены также разделы по определению эпидемиологических маркеров штаммов энтеробактерий.
Принятые в тексте сокращения:
УПЭ - условно патогенные энтеробактерии;
ЭПЭ - энтеропатогенные эшерихии;
ЭМС - агар с эозин-метиленовым синим;
ВСА - висмут-сульфит агар;
ИХН - изотонический раствор хлорида натрия;
СПА - слабощелочной питательный агар;
СПБ - слабощелочной питательный бульон;
РПГА - реакция пассивной гемагглютинации.
1. Идентификацию выделенных энтеробактерий по биохимическим свойствам до уровня рода и вида проводят во всех бактериологических лабораториях санитарно-эпидемиологических станций и лечебно-профилактических учреждений.
2. Серологическую идентификацию шигелл до уровня сероваров (и подсероваров), сальмонелл - до сероваров, энтеропатогенных эшерихий - до ОК-серогрупп проводят во всех указанных лабораториях.
3. Исследования с целью серологической диагностики заболеваний (бактерионосительства) проводят по указанию клинициста или эпидемиолога во всех указанных лабораториях.
4. Определение эпидемиологических маркеров штаммов упомянутых патогенных энтеробактерий - биоваров, сероваров (энтеропатогенных эшерихий), фаговаров, колициногеноваров, колициноваров - проводят по эпидемиологическим показаниям и наличии соответствующих условий в лабораториях республиканских, краевых, областных, городских (в городах с районным делением) санитарно-эпидемиологических станций.
5. Определение сероваров и биоваров условно патогенных энтеробактерий проводят по эпидемиологическим показаниям в лабораториях, перечисленных в п.4.
1. КЛАССИФИКАЦИЯ И НОМЕНКЛАТУРА ЭНТЕРОБАКТЕРИЙ
В настоящее время определение таксономических категорий в бактериологии основано на сочетании морфологических, тинкториальных, биохимических, генетических и других биологических характеристик.
* На русском языке издан его сокращенный вариант - Краткий определитель бактерий Берги (1980).
С целью унификации и правильности написания названий бактерий Международным кодексом номенклатуры бактерий (1975) сформулированы определенные правила. В частности, наименование бактерий следует писать только по-латыни, при этом род - с заглавной буквы, а видовой эпитет - со строчной. Например: Salmonella typhi, или сокращенно S. typhi. Рекомендовано также при внутривидовой дифференциации употреблять термины фаговар вместо фаготип, серовар вместо серотип и т.д.
Семейство Enterobacteriaceae объединяет обширную группу грамотрицательных палочек подвижных или неподвижных, образующих или не образующих капсулы, некислотоустойчивых, не образующих спор, аэробов или факультативных анаэробов. Они образуют кислоту при ферментации глюкозы, цитохромоксидазоотрицательны, восстанавливают нитраты до нитритов (кроме некоторых штаммов Erwinia). Характеристики отдельных родов и видов приведены далее.
В таблице 1 представлены основные таксономические категории и номенклатура энтеробактерий.
Таблица 1. Классификация семейства Enterobacteriaceae
(по Bergey's Manual of Determinative Bacteriology, 1974)
Группа (особое обозначение)
2. O. intermedius
1. B. dysenteriae
3. K. rhinoscleromatia
5. P. inconstans
(Providencia)
2. Y. pseudotuberculosis
3. Y. enterocolitica
Классификация семейства Enterobateriaceae, предложенная Юингом (W.Ewing, 1967-1972) и имеющая признание до настоящего времени, по некоторым позициям расходится с Определителем бактерий Берги. Поэтому считаем необходимым указать на наиболее существенные расхождения.
Так, в Определителе Берги не упоминается Klebsiella oxytoca, фактически представляющая биовар K. pneumoniae, отличающийся по тестам на индол и желатин. В классификации Юинга K. oxytoca рассматривают как самостоятельный вид. В роду Serratia по Берги имеется единственный вид - S. maroescens, а Юингом в этот род включены еще два вида: S. liquefaciens и позднее S. rubideae. У Берги имеется вид Proteus inconstans, по Юингу это род Providencia. В Определителе Берги в род Citrobacter включены два вида: C.freundii и C.intermedius. У Юинга имеется третий вид - C. diversus, который является биоваром C. intermedius.
Эти сопоставления приведены лишь для справок, так как в "Методических указаниях. " принята классификация по Берги.
2. БАКТЕРИОЛОГИЧЕСКАЯ ДИАГНОСТИКА
Бактериологическому исследованию на наличие энтеробактерий может быть подвергнут различный материал, получаемый от людей; показания к его исследованию, правила взятия, подготовки к посеву и выбор питательных сред различны. Однако, начиная с отбора колоний на пластинчатых средах, последующие этапы бактериологического исследования (определение родовой, видовой принадлежности выделенных культур, их серологических характеристик и др.) идентичны (см. схему 1).
2.1. Материал для исследования
Обоснованные показания к проведению бактериологического исследования того или иного материала и правильное его взятие в значительной мере определяют эффективность действий бактериолога. В определении характера подлежащих исследованию материалов, сроков их взятия ведущее значение принадлежит врачам-клиницистам и эпидемиологам. Основные показания к исследованию различных клинических материалов приведены в табл.2.
Таблица 2. Показания к бактериологическим исследованиям различного клинического материала
БАКТЕРИОЛОГИЧЕСКАЯ ДИАГНОСТИКА ДИСБАКТЕРИОЗА КИШЕЧНИКА
Заместитель Начальника Главного управления научно-исследовательских институтов и координации научных исследований Н.А.Демидов 14 апреля 1977 года
Методические рекомендации подготовлены Московским научно-исследовательским институтом эпидемиологии и микробиологии МЗ РСФСР.
Тактика лечения любого болезненного процесса зависит от знания его причин. В раскрытии этиологии кишечных заболеваний решающее значение имеют результаты бактериологического исследования. Особые трудности представляет расшифровка острых, и особенно длительно протекающих кишечных заболеваний, инфекционную природу которых нельзя доказать ни бактериологически, ни эпидемиологически. А тот факт, что в последние годы значительно ухудшились результаты антибиотикотерапии кишечных заболеваний, является одним из аргументов против инфекционной природы определенного числа кишечных расстройств.
Учитывая, что этиологически нерасшифрованные заболевания составляют 40-50% общей суммы кишечных расстройств, раскрытие их природы требует большого внимания микробиологов, инфекционистов, эпидемиологов. Становится очевидным, что проблема борьбы с кишечными заболеваниями требует новых подходов для понимания причин дисфункции кишечника при отсутствии выделения патогенных энтеробактерий - шигелл, сальмонелл.
К настоящему времени общепризнано, что при установлении природы кишечных расстройств нельзя игнорировать значение состава микрофлоры кишечника для его нормальной функциональной деятельности. Макроорганизм и населяющая его микрофлора, в том числе кишечника, являются сбалансированной экологической системой. Более того, в самом кишечном биоценозе существуют коррелятивные связи между отдельными родами, видами бактерий. Качественное или количественное изменение одного из компонентов биоценоза оказывает влияние на всю систему в целом. Нарушение же сложившегося в процессе эволюции биологического равновесия между микробной флорой и организмом не может быть для последнего безразличным. Поэтому при затяжных кишечных заболеваниях следует учесть, что они могут поддерживаться развившимся дисбактериозом кишечника. Это должно явиться основанием для определения в этих случаях качественного и количественного состава кишечной микрофлоры.
Накопленные наблюдения не только об отсутствии эффекта от этиотропной терапии (антибиотиками, химиопрепаратами) значительного числа острых, и особенно хронических, кишечных заболеваний, но об усугублении и более длительном течении болезненного процесса на фоне развившегося при этом дисбактериоза кишечника привели к тому, что в последние годы кишечные заболевания, связанные с дисбактериозом, получили самостоятельное место в клинике.
Установление роли дисбактериоза в патогенезе кишечных расстройств весьма важно и с эпидемиологических позиций. Кишечные заболевания, развившиеся на фоне дисбактериоза, не нуждаются в комплексе противоэпидемических мероприятий, применяемых при заболеваниях инфекционной природы.
Таким образом, показаниями к исследованию состояния кишечной бактериальной флоры являются:
1. Длительно протекающие кишечные расстройства, при которых не удается выделить патогенные энтеробактерии;
2. Затянувшийся период реконвалесценции после перенесенной острой дизентерии и других кишечных инфекций;
3. Дисфункция кишечника на фоне применения антибиотиков разными контингентами больных или длительного контакта с антибактериальными препаратами (на производстве антибиотиков, медперсонала и др.).
Первое издание методических материалов по бактериологической диагностике дисбактериоза кишечника 1969 года нашло применение как в научно-исследовательских, так и в практических диагностических лабораториях. Однако тираж первого издания не мог удовлетворить запросы специалистов. Кроме того, за прошедший период накоплены дополнительные материалы, которые вошли во второе издание.
1. МИКРОФЛОРА КИШЕЧНИКА ЗДОРОВОГО ЧЕЛОВЕКА
Организм человека находится в постоянном взаимодействии с окружающей средой. Между тем из огромного числа микроорганизмов, непрерывно попадающих в пищеварительный тракт человека, только определенные роды, виды микробов нашли в кишечнике человека благоприятные условия существования; в процессе длительной эволюции они закрепились в кишечнике и составили его облигатную микрофлору, выполняющую важные для организма физиологические функции. Нельзя при этом не учесть, что отдельные факторы, такие как характер питания, сезон года, возраст, оказывают некоторое влияние на состав микрофлоры кишечника. С возрастом, например, происходит сдвиг в сторону увеличения грамположительной, гемолитической микрофлоры. Однако колебания, связанные с этими воздействиями, невелики, а способность здорового организма к саморегуляции обеспечивает быстрое восстановление относительного постоянства нормального биоценоза.
Из представителей облигатной микрофлоры кишечника прежде всего следует назвать бифидобактерии (Bifidobacterium) среди анаэробных микробов и кишечную палочку (Escherichia) - среди аэробных.
Основную микрофлору здоровых новорожденных детей, находящихся на естественном вскармливании, составляют бифидобактерии, которые обнаруживаются в больших разведениях фекалий (10-10). Количество их составляет 85-95% числа всех микробов кишечника. Число кишечных палочек в стуле у этих детей невелико. При переходе на прикорм и более разнообразную пищу увеличивается количество кишечной палочки, ацидофильных микробов, энтерококка. Вместе с тем в противовес существовавшему ранее представлению о преобладании анаэробных микробов только у детей, находящихся на грудном вскармливании, установлено, что полного вытеснения бифидобактерии не происходит, в норме они продолжают оставаться в толстом кишечнике в значительных количествах в течение всей жизни человека. Основные различия микрофлоры детей раннего возраста и старших контингентов в разных количественных соотношениях бифидобактерий и кишечной палочки.
У детей ясельного возраста аэробная кишечная микрофлора характеризуется еще более высоким содержанием кишечной палочки, энтерококка. У небольшого числа детей этого возраста выделяются лактозодефективные энтеробактерии и стафилококк. Среди аэробных энтеробактерий у здоровых детей, по данным Н.Д.Стерлиговой (1975), в фекалиях обнаруживаются кроме эшерихий и другие условно-патогенные бактерии семейства кишечных. Так, микробы рода Proteus выделяют 6-7% детей, каждый из родов Citrobacter, Enterobacter, Serratia - 1,0-1,4% здоровых детей. В анаэробной микрофлоре, как и у детей раннего возраста, преобладают бифидобактерии.
У здоровых взрослых людей в 1,5% случаев обнаруживается кишечная палочка со сниженными ферментативными свойствами в первой генерации, которая растет на среде Эндо в виде бледно-розовых колоний. При последующем пересеве (вторая генерация) выделенная культура расщепляет лактозу до конца; количество ее в среднем составляет 21 млн./г фекалий. Гемолизирующие эшерихии, как правило, в фекалиях здоровых людей не обнаруживаются.
Лактозонегативные энтеробактерии обнаружены у 5,1% обследованных здоровых лиц (в среднем 24,9 млн./г). Последующая идентификация выделенных с первичного посева культур как из лактозонегативных, так и лактозоположительных колоний позволяет установить, что у взрослых людей среди представителей аэробной микрофлоры обнаруживаются различные роды условно-патогенных энтеробактерий, например, Citrobacter - у 3%, Enterobacter - у 1-1,5% и т.д. Однако определить количественное содержание каждого из указанных родов в 1 г фекалий не представляется возможным, так как подавляющее большинство этих родовых групп условно-патогенных энтеробактерий содержат варианты как ферментирующие, так и не ферментирующие лактозу; поэтому в первичном посеве трудно определить процентное содержание микробов каждого из этих родов энтеробактерий.
Энтерококк обнаружен у 20% взрослых людей при среднем количестве 634 млн./г. Энтерококк представляет собой диплококки удлиненной формы, более полиморфные, чем стрептококк и пневмококк; окрашивается положительно по Граму, неподвижен, желатин не разжижает, молоко не створаживает. Энтерококк в отличие от стрептококка дает в бульоне диффузный рост. От стрептококка его можно дифференцировать по ряду тестов: энтерококк разлагает маннит, растет на средах, содержащих 40% желчи, в молоке с 0,1% метиленовой сини редуцирует последнюю, устойчив к воздействию высокой температуры (до 60°).
Негемолизирующий и гемолизирующий стафилококк выделяют 2,2-1,5% взрослых людей, при этом средние числовые показатели негемолизующего стафилококка во много раз больше, чем гемолизирующего - 417 млн./г и 90 млн./г соответственно.
Грибы рода кандида почти, как правило, в посевах фекалий здоровых людей не обнаруживаются.
Молочнокислые микробы представляют сборную группу микроорганизмов, в которую входят ацидофильная и другие молочнокислые палочки, молочнокислые стрептококки, стрептобактерии. Они окрашиваются по Граму положительно, спор не образуют, неподвижны, молоко створаживают. Молочнокислые микробы требуют для культивирования сложных по составу питательных сред.
В анаэробной микрофлоре кишечника здорового человека облигатными являются бифидобактерии. Они обнаружены у 92,7% взрослых людей. Количественное содержание их значительно: в 96,1% проб они выделены из фекалий, разведенных до 10, т.е. в 1 г фекалий они составляют сотни миллиардов микробных тел. Морфологически бифидобактерии имеют разветвления на концах палочек, могут быть в форме римской цифры V или гантелей с колбовидными утолщениями на концах, часто скопления их имеют вид китайских иероглифов. Бифидобактерии окрашиваются по Граму положительно (редко встречаются и грамотрицательные), образуют кислоту без газообразования на средах с лактозой, глюкозой, сахарозой; неподвижны, молоко не створаживают, индол и сероводород не образуют, растут только в анаэробных условиях, спор не образуют.
При посевах фекалий в анаэробных условиях вырастает также значительное количество бесспоровых грамотрицательных палочек, которые объединены в группу бактероидов. Палочки весьма полиморфны, могут иметь и кокковидную форму. Эта группа микробов очень мало изучена. В отношении их нет четкой классификации. О физиологической роли бактероидов для организма человека сведений достаточных нет. Слабая изученность этой группы бактерий объясняется трудностями культивирования - применения сложных питательных сред и условий строгого анаэробиоза.
Физиологическое значение нормобиоценоза велико и многообразно. Кишечная палочка, бифидобактерии характеризуются высокоантагонистическими свойствами, препятствующими развитию патогенных и ряда необычных для нормальной микрофлоры кишечника условно-патогенных микробов; тем самым барьерное действие нормальной микрофлоры кишечника можно рассматривать как один из факторов естественной резистентности организма. Известна также витаминообразующая функция нормальной микрофлоры кишечника - способность синтезировать ряд витаминов, особенно группы В. Нормальная микрофлора кишечника участвует в ферментативных процессах в толстом кишечнике, в частности в процессе расщепления кишечных ферментов - энтерокиназы и щелочной фосфатазы. Таким образом, нормальная кишечная микрофлора способствует поддержанию постоянства биохимической и биологической среды пищеварительного аппарата, обеспечивает его нормальное функционирование.
2. ОСНОВНЫЕ СВЕДЕНИЯ О ДИСБАКТЕРИОЗЕ КИШЕЧНИКА
Термином "дисбактериоз" кишечника определяют такие ассоциации микроорганизмов, которые качественно или количественно либо одновременно в том и другом направлении отличаются от нормального состава микрофлоры за счет исчезновения или снижения числа облигатных ее представителей, с одной стороны, увеличения числа энтеробактерий, отсутствующих или встречающихся в ничтожных количествах в норме, с другой. В итоге такие микробные ассоциации не в состоянии выполнить физиологические функции, осуществляемые нормальным биоценозом кишечника.
К настоящему времени уже известен ряд условий, при которых развивается дисбактериоз кишечника. Это прежде всего при кишечных инфекционных заболеваниях, в частности при дизентерии; при любых других заболеваниях, изменяющих реактивность организма. Клиническими наблюдениями и прямыми экспериментами на животных установлены нарушения нормальной микрофлоры также под влиянием антибиотиков, химиопрепаратов, лучевых воздействий.
Широкое распространение в последние годы дисбактериоза кишечника определяет его важное значение в клинике кишечных расстройств. А.Ф.Билибин трактует дисбактериоз как состояние срыва адаптации, ведущее к нарушению защитных и компенсаторных механизмов. Надо полагать, это имеет особенное значение в раннем детском возрасте при незрелости специфических и неспецифических факторов резистентности.
Что касается характеристики микробных ассоциаций при дисбактериозе кишечника, то таковые не однозначны. При одинаковой клинике могут быть разные микробные ассоциации, и наоборот. Однако можно полагать, что в любом случае снижение числа облигатной микрофлоры, обладающей высокой антагонистической активностью, создает условия для развития тех родов и видов энтеробактерий, размножение которых в нормальных условиях было подавлено конкуренцией активных симбионтов, либо тех микроорганизмов, которые оказались транзиторно в кишечнике. Чаще всего в этих условиях развиваются микробы, которые обладают высокой резистентностью к антибиотикам и менее требовательны к условиям размножения, а именно: гноеродные микробы, в первую очередь стафилококк, гнилостные (микробы рода протея и др.); грибы рода кандида.
Enterobacteriaceae (энтеробактерии, семейство бактерий)
Энтеробактерии (лат. Enterobacteriaceae) — семейство грамотрицательных палочкообразных споронеобразующих бактерий, факультативные анаэробы.
Семейство энтеробактерий включает большое число представителей нормальной микрофлоры человеческого организма и, в то же время, значительное количество патогенных микробов.
Систематика энтеробактерий
Энтеробактерии (Enterobacteriaceae) входят в порядок энтеробактерии (лат. Enterobacteriales), класс гамма-протеобактерии (лат. γ proteobacteria), тип протеобактерии (лат. Proteobacteria), царство бактерии.
По современным представлениям в состав Enterobacteriaceae входят следующие роды бактерий: Atlantibacter, Biostraticola, Buttiauxella, Cedecea, Citrobacter (цитробактер), Cronobacter, Enterobacillus, Enterobacter (энтеробактер), Escherichia (эшерихии), Franconibacter, Gibbsiella, Izhakiella, Klebsiella (клебсиеллы), Kluyvera, Kosakonia, Leclercia, Lelliottia, Mangrovibacter, Pluralibacter, Pseudocitrobacter, Raoultella, Rosenbergiella, Salmonella (сальмонеллы), Shigella (шигеллы), Shimwellia, Siccibacter, Trabulsiella, Yokenella.
В качестве кандидатов рассматриваются роды: Aschnera, Curculioniphilus, Cuticobacterium, Gillettellia, Ishikawaella, Macropleicola, Moranella, Phlomobacter, Profftia, Riesia, Rohrkolberia, Schneideria, Stammerula.
До недавнего времени состав родов семейства энтеробактерий был следующий: Alishewanella, Alterococcus, Aquamonas, Aranicola, Arsenophonus, Averyella, Azotivirga, Brenneria, Buchnera, Budvicia, Buttiauxella, Cedecea, Citrobacter, Dickeya, Edwardsiella, Enterobacter, Erwinia, Escherichia, Ewingella, Grimontella, Hafnia, Klebsiella, Kluyvera, Leclercia, Leminorella, Moellerella, Morganella, Obesumbacterium, Pantoea, Pectobacterium, Photorhabdus, Plesiomonas, Pragia, Proteus (протей), Providencia, Rahnella, Raoultella, Salmonella, Samsonia, Serratia, Shewanella, Shigella, Sodalis, Tatumella, Thorsellia, Tiedjeia, Trabulsiella, Wigglesworthia, Xanthomonas, Xenorhabdus, Xylella, Yersinia (иерсинии), Yokenella. Роды Blochmannia и Phlomobacter рассматривались как кандидаты в семейство Enterobacteriaceae.
Примечания. 1. Исходя из соображений определённости и удобства пользования мы ориентируемся на систематику Национального центра биотехнологической информации США (National Center for Biotechnology Information), не утверждая, что она чем-то лучше или хуже других.
2. Неклассифицированные в отдельные виды штаммы, имеющие в своих названиях цифро-буквенные коды и т.п. штаммы и виды в данной статье не приведены.
Энтеробактерии — возбудители заболеваний
- — ряд патогенных серотипов могут быть причиной различных инфекционных заболеваний, протекающих с интоксикацией, лихорадкой, обычно с поражением желудочно-кишечного тракта (различные диареи, в том числе диарею путешественников, геморрагический колит, гемолитико-уремического синдром и другие), реже — мочевыводящих, желчевыводящих путей, других органов или с развитием сепсиса
- Переносчики американского трипаносомоза. Иммунитет при американском трипаносомозе
- Дифференциацильная диагностика причин вертиго (головокружения)
- Лимфангиома глазницы: признаки, гистология, лечение, прогноз
- Лучевая диагностика аплазии и гипоплазии поднижнечелюстной железы
- Измерение ортостатического артериального давления при головокружении. Головокружение и ортостатическая гипотензия
- была причиной кишечной инфекции 2011 года со смертельными исходами в Германии и других странах Европы
Энтеробактерии — представители родов Citrobacier, Enterobacter, Echerichia, Klebsiella, Salmonella могут вызывать инфекции мочеполовой сферы (в том числе циститы, пиелонефриты, острые и хронические простатиты, эпидидимиты и орхиты и т.п.). Бактериурия — наличие бактерий в моче человека может быть только в том случае, если почки, мочевой пузырь или мочеточники инфицированы патогенными бактериями. До 80% бактерий, обнаруживаемых в моче, — энтеробактерии.
Энтеробактерии могут быть причиной вагинитов (воспаления влагалища), цервицитах (воспаления канала шейки матки), других воспалительных гинекологических заболеваниях. Энтеробактерии во влагалище обычно выявляются у пациенток, не соблюдающих правила личной гигиены.
Энтеробактерии могут быть инфекционным агентом при перитоните.
Энтеробактерии — нормальная флора кишечника человека
Энтеробактерии присутствуют в различных отделах желудочно-кишечного тракта здорового человека. Их количество увеличивается от проксимальных отделов (в тощей кишке обнаруживается от 0 до 10 3 КОЕ/мл энтеробактерий, в подвздошной — от 10 2 до 10 6 КОЕ/мл) к дистальным.
Публикации для профессионалов здравоохранения затрагивающие проблематику, связанную с энтеробактериями
Антимикробные препараты, активные в отношении энтеробактерий
По мнению специалистов из исследовательской группы «ДАРМИС» (Палагин И.С. и др.), изучавших осложнённые внебольничные инфекции мочевых путей у взрослых пациентов в России, в отношении всех представителей семейства Enterobacteriaceae среди пероральных препаратов активность 90% и более продемонстрировал только фосфомицин. Наиболее активными в отношении всех представителей семейства Enterobacteriaceae среди парентеральных антибиотиков также оказались карбапенемы. При этом было установлено, что у больных с осложнённой внебольничной инфекцией мочевых путей, среди всех выделенных из мочи штаммов от взрослых пациентов, доля представителей семейства Enterobacteriaceae составила около 80%.
Читайте также:
